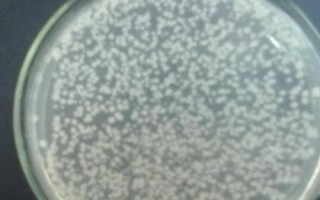
枯草芽孢杆菌和矿源黄腐酸钾能混用吗，可以混用

溴氰菊酯有什么作用,是一种常见的杀虫药
溴氰菊酯属于杀虫药。溴氰菊酯适合对棉花、苹果、柿子、茶树等作物使用,可防治棉铃虫、小菜蛾、菜青虫、刺蛾类、螟虫类等多种害虫。溴氰菊酯的主要用法是喷雾,也可以拌入土壤中配制成毒土,然后撒施。一、溴氰菊酯...
10-12
枯草芽孢杆菌和矿源黄腐酸钾混用时,需注意二者的用量及使用时间,同时最好是先施加矿源黄腐酸钾,待其在土壤中充分分解后再施加枯草芽孢杆菌微生物菌剂。

1、实验表明,矿源黄腐酸钾与枯草芽孢杆菌微生物菌剂混用可行。混用后,可以显著增强两者的作用效果,提高作物的生长速度和营养吸收能力。同时,枯草芽孢杆菌微生物菌剂的施用可以增加土壤中有益菌群的数量和种类,从而提高土壤的健康程度和生物多样性。
2、在混用矿源黄腐酸钾和枯草芽孢杆菌微生物菌剂时,需要注意两者的用量和施用时间。建议在作物生长的不同阶段分别施用,不同作物的用量也不同。
3、混用时要注意不要将两者混在一起,最好是先施用矿源黄腐酸钾,待其在土壤中充分分解后再施用枯草芽孢杆菌微生物菌剂。
1、枯草芽孢杆菌的作用
(1)可以提高作物的抗病、抗寒、抗旱能力。
(2)可提高土壤的养分,改良土壤的结构,提高肥料利用率。
(3)能够促使土壤中的有机质分解成腐殖质,从而刺激作物的生长。
(4)可促进作物生长、成熟、降低成本、增加产量、提高收入。
(5)有一定的固氮、解磷、解钾的作用。

2、枯草芽孢杆菌的使用方式
(1)可防治稻瘟病、纹枯病、稻曲病。可在水稻孕穗破口期和齐穗期各施药一次,每亩使用枯草芽孢杆菌10克,间隔7-12天,均匀喷雾即可。
(2)枯草芽孢杆菌可以跟咪鲜胺、三环唑、井冈霉素等混用,有较好的相互增效作用。在病害集中、急性暴发时,更加能体现出混用的效果。

1、枯草芽孢杆菌防治对象:青枯病、溃疡病、性软腐、性穿孔等性病害。
2、枯草芽孢杆菌广泛适用于果树、蔬菜、园林花卉、中药材及大田作物。尤其适合无公害、绿色产品的生产。
相关文章
溴氰菊酯属于杀虫药。溴氰菊酯适合对棉花、苹果、柿子、茶树等作物使用,可防治棉铃虫、小菜蛾、菜青虫、刺蛾类、螟虫类等多种害虫。溴氰菊酯的主要用法是喷雾,也可以拌入土壤中配制成毒土,然后撒施。一、溴氰菊酯...
10-12
正确掌握用药时期和剂量:根据杂草类型适时喷药,药物的用量取决于其中的有效成分,使用前应先进行试验。严格操作规程:喷药前要仔细阅读说明书,喷药时要使用专用的设备,药液应均匀喷雾,不可接触作物的叶片和枝干...
03-07
肉眼鉴别:生物有机肥一般呈褐色或黑褐色,色泽比较单一,而其他有机肥的颜色与生产操作方式有关,比如精制有机肥一般为粪便原色。水浸闻味:生物有机肥放入盛有水的杯子内后,不会散发出臭味,而精制有机肥以及农家...
08-15
化肥与有机肥混用具有提高肥料的综合效应、增加作物的氮素营养、缓解肥害、互补优势、净化环境等好处。提高肥料的综合效应:混用化肥和有机肥,可加快有机肥的腐熟速度,吸附化肥里面的营养元素,提高肥料的利用率。...
11-29
基肥:可直接将绿叶宝肥料撒施在土表,然后结合耕翻翻入土中,也可以先耕翻土壤,然后再施加肥料并混匀。追肥:绿叶宝肥料用清水稀释后,直接进行叶面喷施(可配合氮肥使用)。适用对象:适用于文竹、君子兰、榕树以...
12-21
地下害虫防治方法包括药剂拌种、毒土撒施、毒饵诱杀、喷药防治等。药剂拌种:常见拌种剂有3911、甲拌磷、辛硫磷等,用量为种子重量0.1-0.3%。毒土撒施:使用40%乐斯本或75%辛硫磷乳油、20%除虫...
03-10
过量施磷肥,作物吸收的磷元素会超出正常范围,此时它们的呼吸作用会变得过于旺盛,干物质的消耗速度大于积累速度,导致繁殖器官超前发育,继而引发早熟、籽粒小、产量下降的情况。土壤缺锌时,过量施磷肥会产生磷酸...
07-18
生产中留瓜多、施肥不当、打药过量、浇水不当、采收不及时等原因会导致黄瓜开花不结果。生产中留瓜多:没有摘除多余的雌花,也没有疏果。施肥不当:复混肥的用量过多,增加了土壤中的肥料浓度,影响到黄瓜根系对养分...
06-28
氯虫苯甲酰胺为酰胺类新型杀虫剂,具内吸、胃毒、触杀作用,但以胃毒为主,可用于防治玉米螟、甜瓜野螟、瓜野螟、黏虫、棉铃虫、甜菜夜蛾、马铃薯块茎蛾、粉纹夜蛾、菜青虫、烟青虫等多种害虫。氯虫苯甲酰胺毒性较低...
06-04
部分杀菌剂、杀螨剂、拟除虫菊酯类杀虫剂、有机氮杀虫剂、有机磷制剂等遇碱容易分解。杀菌剂:稻瘟净、托布津、敌克松等杀菌剂遇碱不稳定。杀螨剂:三氯杀螨醇遇碱容易分解。拟除虫菊酯类杀虫剂:敌杀死、杀灭菊酯等...
12-13
热点文章
登海1810玉米栽培技术要点,适宜播期在6月上旬为宜
京单68玉米栽培技术要点,在京津唐地区出苗至成熟98天
德沃1号玉米栽培技术要点,种植密度不宜过大
喂鸡用生米还是熟米饭,生米和熟米饭均可饲喂
溪黄草的繁殖方法,可种子、扦插、分株繁殖
滇宝153玉米栽培技术要点,春播适宜在4月上中旬播种
贵卓玉806玉米栽培技术要点,中抗灰斑病
庆麦101小麦栽培技术要点,属弱春性品种